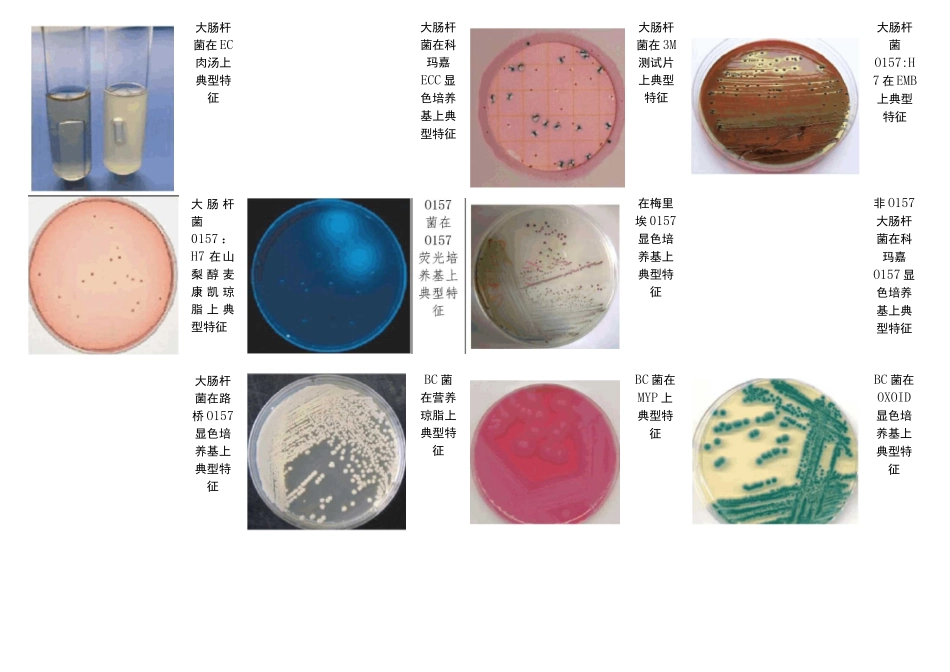
微生物标准菌株图谱_第2页
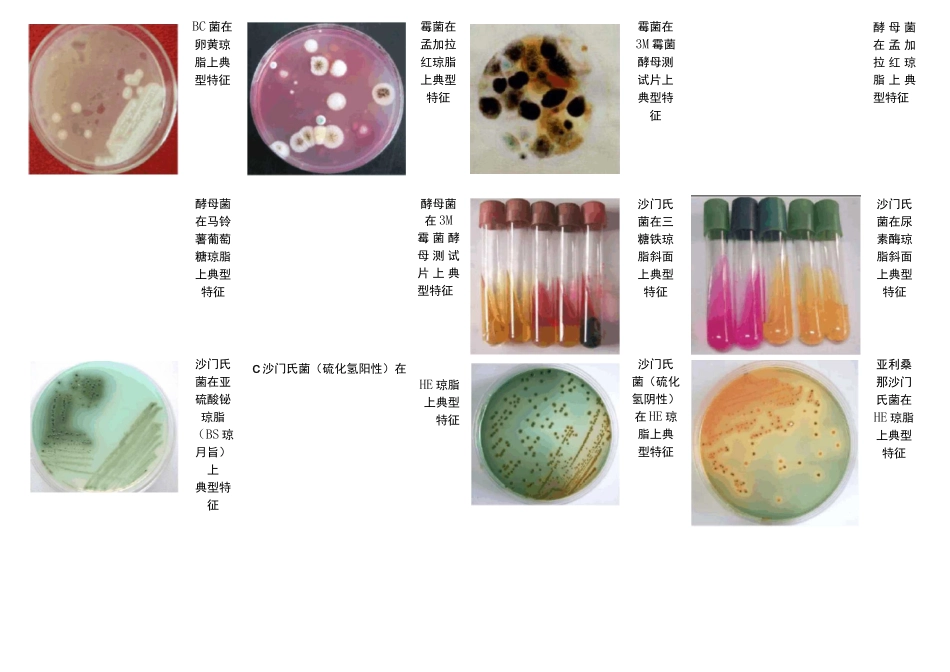
微生物标准菌株图谱_第3页

细菌在TTC营养琼脂上典型特征蔓延菌在平板计数琼脂上典型特征好氧菌在3M细菌总数测试片上典型特征大肠菌群在去氧胆酸盐琼脂(DC)上典型特征大肠菌群在LST上典型特征大肠菌群在VRBA上典型特征大肠杆菌0157菌在海博O157菌显色培养基上典型特征大肠杆菌在EMB上典型特征大肠菌群在3M测试片上典型特征大肠菌群在科玛嘉ECC显色培养基上典型特征大肠菌群在OXOID选择性大肠菌群/杆菌显色培养基上特征大肠杆菌在大肠杆菌/大肠菌群显色培养基上典型特征大肠杆菌在EC肉汤上典型特征大肠杆菌0157:H7在山梨醇麦康凯琼脂上典型特征大肠杆菌在路桥O157显色培养基上典型特征大肠杆菌在科玛嘉ECC显色培养基上典型特征BC菌在营养琼脂上典型特征大肠杆菌在3M测试片上典型特征在梅里埃0157显色培养基上典型特征BC菌在MYP上典型特征大肠杆菌O157:H7在EMB上典型特征非O157大肠杆菌在科玛嘉O157显色培养基上典型特征BC菌在OXOID显色培养基上典型特征BC菌在卵黄琼脂上典型特征霉菌在孟加拉红琼脂上典型特征霉菌在3M霉菌酵母测试片上典型特征酵母菌在孟加拉红琼脂上典型特征酵母菌在马铃薯葡萄糖琼脂上典型特征酵母菌在3M霉菌酵母测试片上典型特征沙门氏菌在三糖铁琼脂斜面上典型特征沙门氏菌在尿素酶琼脂斜面上典型特征沙门氏菌在亚硫酸铋琼脂(BS琼月旨)上典型特征C沙门氏菌(硫化氢阳性)在HE琼脂上典型特征沙门氏菌(硫化氢阴性)在HE琼脂上典型特征亚利桑那沙门氏菌在HE琼脂上典型特征柠檬杆其他乳沙门氏沙门氏菌在HE糖阳性菌在ws菌在琼脂上硫化氢彳i病■耳
琼脂上XLD琼*二・:匕典型特Zjfl*rHi/-阴性的a典型特--r、脂上典征肠道菌««征■I型特征W*::在HE■-・1■■+s"*/琼脂上典型特征■广Jl沙门氏沙门氏亚利桑其他乳«菌(硫JF肥
*■“、'h菌(硫那沙门
:::f糖阳性,